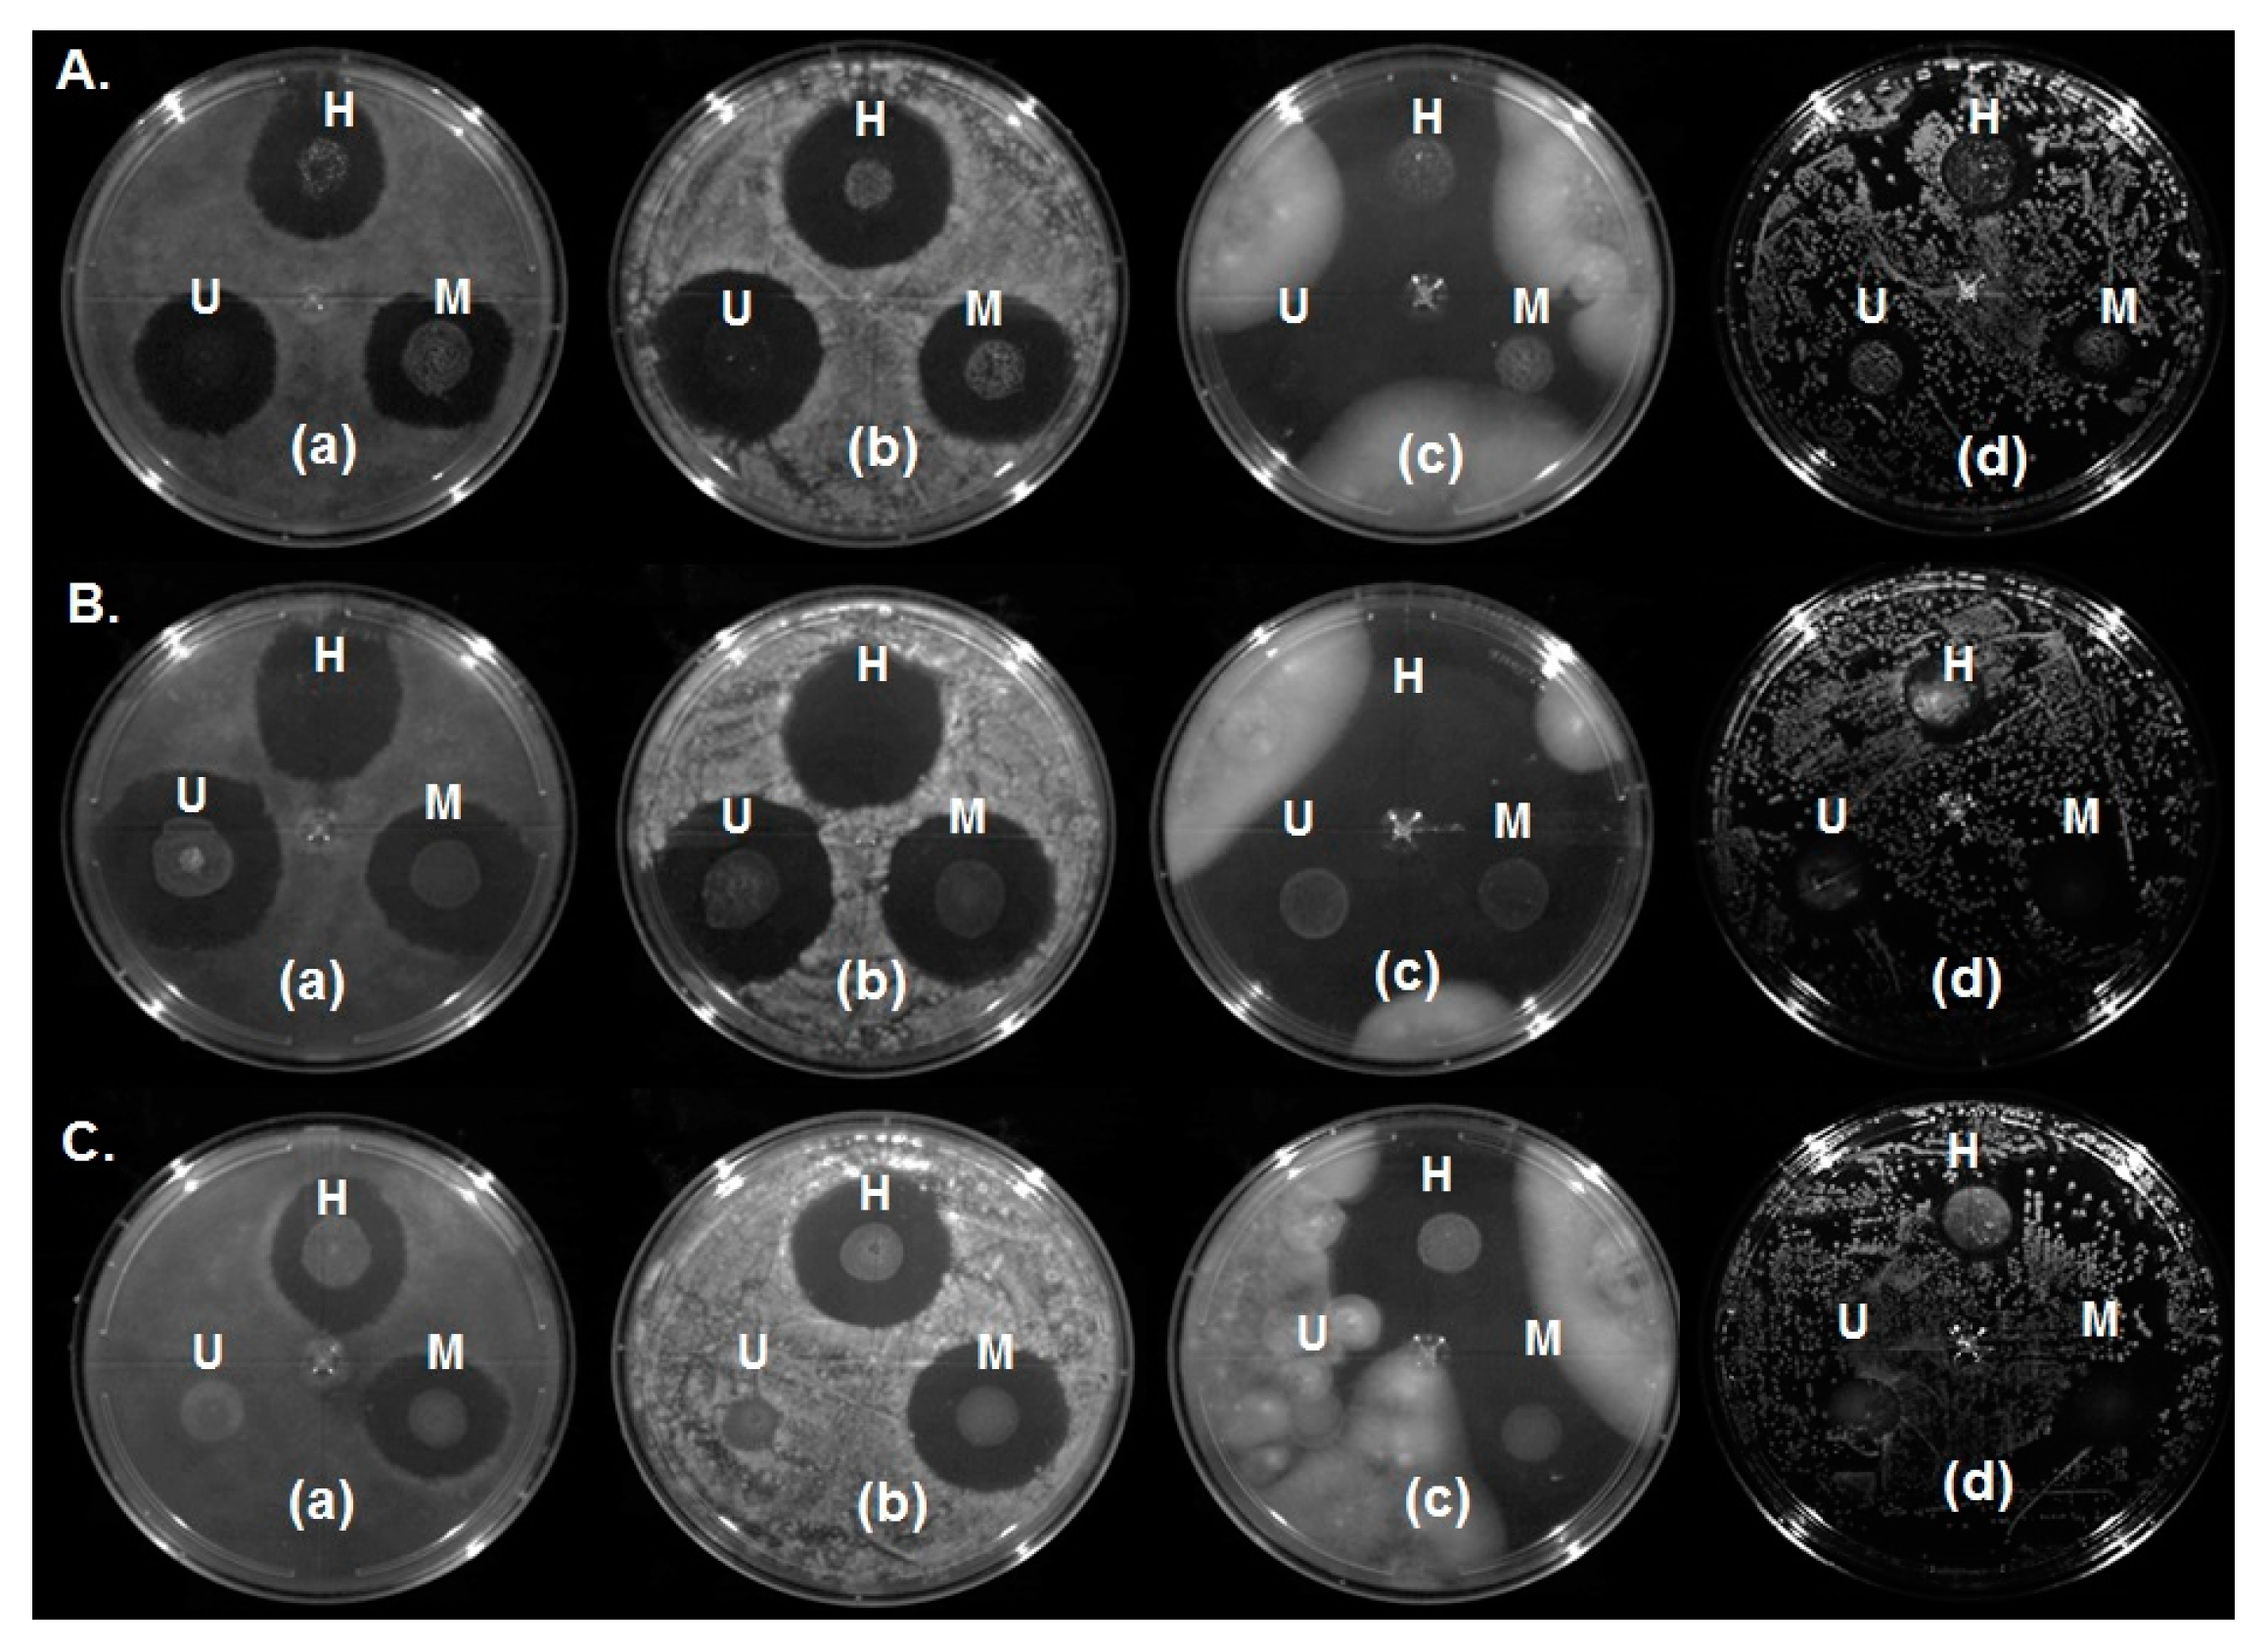
Ijms 18 02712 g008 Ijms 18 02712 g008

Physicochemical and Antimicrobial Characterization of Beeswax–Starch Food-Grade Nanoemulsions Incorporating Natural Antimicrobials
Abstract
1. Introduction
2. Results and Discussion
2.1. Thermal Properties
2.2. Physicochemical Characterization of BW–SN
2.2.1. Droplet Size, Polydispersity Index (PDI) and Size Distribution
2.2.2. ζ-Potential
2.2.3. pH
2.2.4. Whiteness Index (WI)
2.3. Transmission Electron Microscopy (TEM)
2.4. Rheological Characterization
Viscoelastic Properties
2.5. Wettability
2.5.1. , and
2.5.2. Wettability Coefficient
2.6. Antimicrobial Effect
3. Materials and Methods
3.1. Chemicals
3.2. Microorganisms
3.3. Culture Media
3.4. BW Thermal Analysis
3.5. BW–Starch Nanoemulsion (BW–SN) Formation
3.6. Physicochemical Characterization of BW–SN
3.6.1. Particle Size and PDI
3.6.2. ζ-Potential
3.6.3. pH
3.6.4. Color
3.7. TEM
3.8. Rheological Behavior of BW–SN
3.9. Wettability of BW–SN
3.9.1. Solid–Vapor Surface Tension (
3.9.2. Liquid–Vapor Surface Tension ()
3.9.3. Solid–Liquid Surface Tension ()
3.10. Antimicrobial Activity of BW–SN
3.11. Statistical Analysis
4. Conclusions
Acknowledgments
Author Contributions
Conflicts of Interest
Abbreviations
| BW | Beeswax |
| OS | Oxidized starch |
| SN | Starch nanoemulsions |
| SA | Stearic acid |
| T80 | Tween 80 |
| S60 | Span 60 |
| LAE | Lauric arginate ester |
| NAT | Natamycin |
| PDA | Potato dextrose agar |
| TSA | Tryptone soy agar |
| DSC | Differential scanning calorimeter |
| DLS | Dynamic light scattering |
| PALS | Phase-analysis light scattering |
| PDI | Polydispersity index |
| WI | Whiteness index |
| TEM | Transmission electron microscopy |
| Ws | Wettability coefficient |
| Wa | Adhesive forces |
| Wc | Cohesive forces |
| Toc | Crystallization onset temperature |
| Tc | Maximum crystallization peak |
| Tom | Melting onset temperature |
| Tm | Maximum melting peak |
References
- Cushen, M.; Kerry, J.; Morris, M.; Cruz-Romero, M.; Cummins, E. Nanotechnologies in the food industry-recent developments, risks and regulation. Trends Food Sci. Technol. 2012, 24, 30–46. [Google Scholar] [CrossRef]
- Momin, J.K.; Joshi, B.H. Nanotechnology in Foods. In Nanotechnologies in Food and Agriculture; Rai, M., Ribeiro, C., Mattoso, L., Duran, N., Eds.; Springer: New York, NY, USA, 2015; pp. 3–24. [Google Scholar]
- Salvia-Trujillo, L.; Rojas-Graü, A.; Soliva-Fortuny, R.; Martín-Belloso, O. Use of antimicrobial nanoemulsions as edible coatings: Impact on safety and quality attributes of fresh-cut Fuji apples. Postharvest Biol. Technol. 2015, 105, 8–16. [Google Scholar] [CrossRef]
- Arredondo-Ochoa, T.; García-Almendárez, B.E.; Amaro-Reyes, A.; Rivera-Pastrana, D.M.; Gutiérrez-López, G.F.; Martín-Belloso, O.; Regalado-Gonzalez, C. Design and characterization of corn starch edible films including beeswax and natural antimicrobials. Food Bioprocess Technol. 2017, 10, 103–114. [Google Scholar] [CrossRef]
- Sagalowicz, L.; Leser, M.E. Delivery systems for liquid food products. Curr. Opin. Colloid Interface Sci. 2010, 15, 61–72. [Google Scholar] [CrossRef]
- Gutiérrez, J.M.; González, C.; Maestro, A.; Solè, I.; Pey, C.M.; Nolla, J. Nano-emulsions: New applications and optimization of their preparation. Curr. Opin. Colloid Interface Sci. 2008, 13, 245–251. [Google Scholar] [CrossRef]
- Qian, C.; McClements, D.J. Formation of nanoemulsions stabilized by model food-grade emulsifiers using high-pressure homogenization: Factors affecting particle size. Food Hydrocoll. 2011, 25, 1000–1008. [Google Scholar] [CrossRef]
- Donsì, F.; Annunziata, M.; Sessa, M.; Ferrari, G. Nanoencapsulation of essential oils enhance their antimicrobial activity in foods. LWT-Food Sci. Technol. 2011, 44, 1908–1914. [Google Scholar] [CrossRef]
- Delmas, T.; Piraux, H.; Couffin, A.C.; Texier, I.; Vinet, F.; Poulin, P.; Cates, M.E.; Bibette, J. How to prepare and stabilize very small nanoemulsions. Langmuir 2011, 27, 1683–1692. [Google Scholar] [CrossRef] [PubMed]
- McClements, D.J. Context and Background. In Food Emulsions: Principles, Practices, and Techniques, 3rd ed.; CRC Press: New York, NY, USA, 2016; pp. 1–26. [Google Scholar]
- Mason, T.G.; Wilking, J.N.; Meleson, K.; Chang, C.B.; Graves, S.M. Nanoemulsions: Formation, structure, and physical properties. Phys. Condens. Matter 2006, 18, R635–R666. [Google Scholar] [CrossRef]
- McClements, D.J.; Rao, J. Food-grade nanoemulsions: Formulation, fabrication, properties, performance, biological fate, and potential toxicity. Crit. Rev. Food Sci. Nutr. 2011, 51, 285–330. [Google Scholar] [CrossRef] [PubMed]
- Kralova, I.; Sjöblom, J. Surfactants used in food industry: A review. J. Dispers. Sci. Technol. 2009, 30, 1363–1383. [Google Scholar] [CrossRef]
- Silva, H.D.; Cerqueria, M.A.; Vicente, A.A. Nanoemulsion for food applications: Development and characterization. Food Bioprocess Technol. 2012, 5, 854–867. [Google Scholar] [CrossRef]
- Attama, A.A.; Shicke, B.C.; Müller-Goymann, C.C. Further characterization of theobroma oil-beeswax admixtures as lipid matrices for improved drug delivery systems. Eur. J. Pharm. Biopharm. 2006, 64, 294–306. [Google Scholar] [CrossRef] [PubMed]
- Aichholz, R.; Lorbeer, E. Investigation of combwax of honeybees with high-temperature gas chromatography and high-temperature gas chromatography-chemical ionization mass spectrometry. I. High-temperature gas chromatography. J. Chromatogr. A 1999, 885, 601–615. [Google Scholar] [CrossRef]
- Buchwald, R.; Breed, M.D.; Greenberg, A.R. The thermal properties of beeswaxes: Unexpected findings. J. Exp. Biol. 2008, 211, 121–127. [Google Scholar] [CrossRef] [PubMed]
- Yilmaz, E.; Ögütcü, M. Properties and stability of hazelnut oil organogels with beeswax and monoglyeride. J. Am. Oil Chem. Soc. 2014, 91, 1007–1017. [Google Scholar] [CrossRef]
- Brar, S.K.; Verma, M. Measurement of nanoparticles by light-scattering techniques. Trends Anal. Chem. 2011, 30, 4–17. [Google Scholar] [CrossRef]
- Kaszuba, M.; McKnight, D.; Connah, M.T.; McNeil-Watson, F.K.; Nobbmann, U. Measuring sub nanometer sizes using dynamic light scattering. J. Nanopart. Res. 2008, 10, 823–829. [Google Scholar] [CrossRef]
- Rao, J.; McClements, D.J. Food-grade microemulsions and nanoemulsions: Role of oil phase composition on formation and stability. Food Hydrocoll. 2012, 29, 326–334. [Google Scholar] [CrossRef]
- Ghosh, V.; Mukherjee, A.; Chandrasekaran, N. Ultrasonic emulsification of food-grade nanoemulsion formulation and evaluation of its bactericidal activity. Ultrason. Sonochem. 2013, 20, 338–344. [Google Scholar] [CrossRef] [PubMed]
- Salvia-Trujillo, L.; Rojas-Graü, A.; Soliva-Fortuny, R.; Martín-Belloso, O. Physicochemical characterization of lemongrass essential oil-alginate nanoemulsions: Effect of ultrasound processing parameters. Food Bioprocess Technol. 2013, 6, 2439–2446. [Google Scholar] [CrossRef]
- Lu, W.; Zhang, Y.; Tan, Y.Z.; Hu, K.L.; Jiang, X.G.; Fu, S.K. Cationic albumin-conjugated pegylated nanoparticles as novel drug carrier for brain delivery. J. Control. Release 2005, 107, 428–448. [Google Scholar] [CrossRef] [PubMed]
- Kaszuba, M.; Corbett, J.; Watson, F.M.; Jones, A. High-concentration zeta potential measurements using light-scattering techniques. Philos. Trans. R. Soc. A 2010, 368, 4439–4451. [Google Scholar] [CrossRef] [PubMed]
- Guerra-Rosas, M.I.; Morales-Castro, J.; Ochoa-Martínez, L.A.; Salvia-Trujillo, L.; Martín-Belloso, O. Long-term stability of food-grade nanoemulsions from high methoxyl pectin containing essential oils. Food Hydrocoll. 2016, 52, 438–446. [Google Scholar] [CrossRef]
- Chanamai, R.; McClements, D.J. Depletion flocculation of beverage emulsions by gum arabic and modified starch. J. Food Sci. 2001, 66, 457–463. [Google Scholar] [CrossRef]
- McClements, D.J.; Xiao, H. Potential biological fate of ingested nanoemulsions: Influence of particle characteristics. Food Funct. 2012, 3, 202–220. [Google Scholar] [CrossRef] [PubMed]
- Mayer, S.; Weiss, J.; McClements, D.J. Behavior of vitamin E acetate delivery systems under simulated gastrointestinal conditions: Lipid digestion and bioaccessibility of low-energy nanoemulsions. J. Colloid Interface Sci. 2013, 404, 215–222. [Google Scholar] [CrossRef] [PubMed]
- Guzey, D.; McClements, D.J. Formation, stability and properties of multilayer emulsions for application in the food industry. Adv. Colloid Interface Sci. 2006, 128–130, 227–248. [Google Scholar] [CrossRef]
- Salvia-Trujillo, L.; Rojas-Graü, A.; Soliva-Fortuny, R.; Martín-Belloso, O. Physicochemical characterization and antimicrobial activity of food-grade emulsions and nanoemulsions incorporating essential oils. Food Hydrocoll. 2014, 43, 547–556. [Google Scholar] [CrossRef]
- Klang, V.; Matsko, N.B.; Valenta, C.; Hofer, F. Electron microscopy of nanoemulsions: An essential tool for characterisation and stability assessment. Micron 2011, 43, 85–103. [Google Scholar] [CrossRef] [PubMed]
- Liang, R.; Xu, S.; Shoemaker, C.F.; Li, Y.; Zhong, F.; Huang, Q. Physical and antimicrobial properties of peppermint oil nanoemulsions. J. Agric. Food Chem. 2012, 60, 7548–7555. [Google Scholar] [CrossRef] [PubMed]
- Hopkins, E.J.; Chang, C.; Lam, R.S.H.; Nickerson, M.T. Effects of flaxseed oil concentration on the performance of soy protein isolate-based emulsion-type film. Food Res. Int. 2015, 67, 418–425. [Google Scholar] [CrossRef]
- Rezvani, E.; Schleining, G.; Sümen, G.; Taherian, A.R. Assessment of physical and mechanical properties of sodium caseinate and stearic acid based film-forming emulsions and edible films. J. Food Eng. 2013, 116, 598–605. [Google Scholar] [CrossRef]
- Fabra, M.J.; Jiménez, A.; Atarés, L.; Talens, P.; Chiralt, A. Effect of fatty acids and beeswax addition on properties of sodium caseinate dispersions and films. Biomacromolecules 2009, 10, 1500–1507. [Google Scholar] [CrossRef] [PubMed]
- Medina-Torres, L.; Santiago-Adame, R.; Calderas, F.; Gallegos-Infante, J.A.; González-Laredo, R.F.; Rocha-Guzmán, N.E.; Núñez-Ramírez, D.M.; Bernad-Bernad, M.J.; Manero, O. Microencapsulation by spray drying of laurel infusions (Litsea glaucescens) with maltodextrin. Ind. Crops Prod. 2016, 90, 1–8. [Google Scholar] [CrossRef]
- Bourbon, A.I.; Pinheiro, A.C.; Ribeiro, C.; Miranda, C.; Maia, J.M.; Teixeira, J.A.; Vicente, A.A. Characterization of galactomannans extracted from seeds of Gleditsia triacanthos and Sophora japonica through shear and extensional rheology: Comparison with guar gum and locust bean gum. Food Hydrocoll. 2010, 24, 184–192. [Google Scholar] [CrossRef]
- Campestrini, L.H.; Silveira, J.L.M.; Duarte, M.E.R.; Koop, H.S.; Noseda, M.D. NMR and rheological study of Aloe barbadensis partially acetylated glucomannan. Carbohydr. Polym. 2013, 94, 511–519. [Google Scholar] [CrossRef] [PubMed]
- Bauer, S.; Schulte, E.; Thier, H.P. Composition of the surface wax from tomatoes. I. Identification of the components by GC/MS. Eur. Food Res. Technol. 2004, 219, 223–228. [Google Scholar] [CrossRef]
- Sánchez-Ortega, I.; García-Almendárez, B.E.; Santos-López, E.M.; Reyes-González, L.R.; Regalado, C. Characterization and antimicrobial effect of starch-based edible coating suspensions. Food Hydrocoll. 2016, 52, 906–913. [Google Scholar] [CrossRef]
- Choi, W.Y.; Park, H.J.; Ahn, D.J.; Lee, J.; Lee, C.Y. Wettability of chitosan coating solution on “fuji” apple skin. J. Food Sci. 2002, 67, 2668–2672. [Google Scholar] [CrossRef]
- Casariego, A.; Souza, B.W.S.; Vicente, A.A.; Teixeira, J.A.; Cruz, L.; Díaz, R. Chitosan coating surface properties as affected by plasticizer, surfactant and polymer concentrations in relation to the surface properties of tomato and carrot. Food Hydrocoll. 2008, 22, 1452–1459. [Google Scholar] [CrossRef]
- Zisman, W.A. Relation of the equilibrium contact angle to liquid and solid constitution. In Contact Angle, Wettability, and Adhesion; Fowkes, F.M., Ed.; Advances in Chemistry; American Chemical Society: Washington, DC, USA, 1964; pp. 1–51. [Google Scholar]
- Cerqueira, M.A.; Lima, A.M.; Teixeira, J.A.; Moreira, R.A.; Vicente, A.A. Suitability of novel galactomannans as edible coatings for tropical fruits. J. Food Eng. 2009, 94, 372–378. [Google Scholar] [CrossRef]
- Ramírez, C.; Gallegos, I.; Ihl, M.; Bifani, V. Study of contact angle, wettability and water vapor permeability in carboxymethylcellulose (CMC) based film with murta leaves (Ugni molinae Turcz) extract. J. Food Eng. 2012, 109, 424–429. [Google Scholar] [CrossRef]
- Skurtys, O.; Velásquez, P.; Henriquez, O.; Matiacevich, S.; Enrione, J.; Osorio, E.F. Wetting behavior of chitosan solutions on blueberry epicarp with or without epicuticular waxes. LWT-Food Sci. Technol. 2011, 44, 1449–1457. [Google Scholar] [CrossRef]
- Jetter, R.; Kunst, L.; Samuels, A.L. Composition of plant cuticular waxes. In Biology of the Plant Cuticle; Riederer, M., Müller, C., Eds.; Blackwell Publishing Ltd.: Oxford, UK, 2006; Volume 23, pp. 145–175. [Google Scholar]
- Teixeira, P.C.; Leite, G.M.; Domingues, R.J.; Silva, J.; Gibbs, P.A.; Ferreira, J.P. Antimicrobial effects of a microemulsion and a nanoemulsion on enteric and other pathogens and biofilms. Int. J. Food Microbiol. 2007, 118, 15–19. [Google Scholar] [CrossRef] [PubMed]
- Hagenmaier, R.D.; Baker, R.A. Wax microemulsions and emulsions as citrus coatings. J. Agric. Food Chem. 1994, 42, 899–902. [Google Scholar] [CrossRef]
- Muscat, D.; Adhikari, R.; McKnight, S.; Guo, Q.; Adhikari, B. The physicochemical characteristics and hydrophobicity of high amylose starch-glycerol films in the presence of three natural waxes. J. Food Eng. 2013, 119, 205–219. [Google Scholar] [CrossRef]
- Santos, T.M.; Pinto, A.M.B.; de Oliveira, A.V.; Ribeiro, H.L.; Caceres, C.A.; Ito, E.N.; Azeredo, H.M. Physical properties of cassava-starch-carnauba wax emulsion films as affected by component proportions. Int. J. Food Sci. Technol. 2014, 49, 2045–2051. [Google Scholar] [CrossRef]
- Vargas, M.; Cháfer, M.; Albors, A.; Chiralt, A.; González-Martínez, C. Physicochemical and sensory characteristics of yogurt produced from mixtures of cows’ and goats’ milk. Int. Dairy J. 2008, 18, 1146–1152. [Google Scholar] [CrossRef]
- Harkins, W.D.; Jordan, H.F. A method for the determination of surface and interfacial tension from the maximum pull on a ring. J. Am. Chem. Soc. 1930, 52, 1751–1772. [Google Scholar] [CrossRef]
- Zuidema, H.H.; Waters, G.W. Ring method for the determination of interfacial tension. Ind. Eng. Chem. Res. 1941, 13, 312–313. [Google Scholar] [CrossRef]
- Zahid, N.; Ali, A.; Manickam, S.; Siddiqui, Y.; Maqbool, M. Potential of chitosan-loaded nanoemulsions to control different Colletotrichum spp. and maintain quality of tropical fruits during cold storage. J. Appl. Microbiol. 2012, 113, 925–939. [Google Scholar] [CrossRef] [PubMed]

| Emulsifier | Process | z-Average (nm) | PDI | pH |
|---|---|---|---|---|
| SA | Homogenization | 244.8 ± 2.1 e | 0.7 ± 0.2 a,b | 8.3 ± 0.0 c |
| Ultrasound | 515.1 ± 5.9 d | 0.5 ± 0.2 c,d | 8.3 ± 0.0 c | |
| Microfluidization | 256.8 ± 3.9 e | 0.6 ± 0.1 c,d | 8.3 ± 0.0 c | |
| T80 | Homogenization | 185.5 ± 8.5 f | 0.3 ± 0.0 b,c,d | 8.6 ± 0.0 a |
| Ultrasound | 111.9 ± 5.6 g | 0.4 ± 0.0 a,b,c | 8.6 ± 0.1 a | |
| Microfluidization | 77.7 ± 6.2 h | 0.3 ± 0.0 d | 8.6 ± 0.0 a | |
| T80/S60 | Homogenization | 913.8 ± 10.6 b | 0.8 ± 0.1 a,b | 8.4 ± 0.0 b |
| Ultrasound | 1054.3 ± 4.0 a | 0.7 ± 0.0 a,b | 8.4 ± 0.1 b | |
| Microfluidization | 891.9 ± 8.9 c | 0.8 ± 0.2 a | 8.3 ± 0.1 b |
| Emulsifier | Process | Contact Angle (θ) | Cos θ | (mN/m) | (mN/m) | (mN/m) |
|---|---|---|---|---|---|---|
| SA | Homogenization | 45.8 | 0.7 | 15.0 | 26.0 | −3.1 |
| Ultrasound | 43.1 | 0.7 | 15.0 | 28.0 | −5.4 | |
| Microfluidization | 40.0 | 0.8 | 15.0 | 29.7 | −7.7 | |
| T80 | Homogenization | 42.2 | 0.7 | 15.0 | 26.6 | −4.6 |
| Ultrasound | 44.1 | 0.7 | 15.0 | 25.8 | −3.4 | |
| Microfluidization | 48.6 | 0.7 | 15.0 | 26.3 | −2.4 | |
| T80/S60 | Homogenization | 41.1 | 0.8 | 15.0 | 31.4 | −8.5 |
| Ultrasound | 38.5 | 0.8 | 15.0 | 30.0 | −8.4 | |
| Microfluidization | 40.2 | 0.7 | 15.0 | 31.4 | −8.9 |
| Emulsifier | Process | Wa (mN/m) | Wc (mN/m) | Ws (mN/m) |
|---|---|---|---|---|
| SA | Homogenization | 44.2 ± 1.2 b | 52.1 ± 1.7 b | −7.9 ± 1.1 a |
| Ultrasound | 48.4 ± 1.8 b | 56.0 ± 1.9 b | −7.6 ± 1.3 a | |
| Microfluidization | 52.4 ± 1.7 b | 59.4 ± 1.0 b | −7.0 ± 1.6 a | |
| T80 | Homogenization | 46.2 ± 2.1 c | 53.2 ± 1.0 c | −7.0 ± 2.0 a |
| Ultrasound | 44.2 ± 2.0 c | 51.5 ± 1.9 c | −7.3 ± 0.6 a | |
| Microfluidization | 43.7 ± 3.3 c | 52.6 ± 1.9 c | −8.9 ± 1.6 a | |
| T80/S60 | Homogenization | 54.9 ± 0.3 a | 62.7 ± 1.0 a | −7.8 ± 1.2 a |
| Ultrasound | 53.4 ± 1.1 a | 59.9 ± 1.0 a | −6.5 ± 0.5 a | |
| Microfluidization | 55.3 ± 4.3 a | 62.7 ± 2.6 a | −7.5 ± 2.2 a |
© 2017 by the authors. Licensee MDPI, Basel, Switzerland. This article is an open access article distributed under the terms and conditions of the Creative Commons Attribution (CC BY) license (http://creativecommons.org/licenses/by/4.0/).
Share and Cite
Arredondo-Ochoa, T.; García-Almendárez, B.E.; Escamilla-García, M.; Martín-Belloso, O.; Rossi-Márquez, G.; Medina-Torres, L.; Regalado-González, C. Physicochemical and Antimicrobial Characterization of Beeswax–Starch Food-Grade Nanoemulsions Incorporating Natural Antimicrobials. Int. J. Mol. Sci. 2017, 18, 2712. https://doi.org/10.3390/ijms18122712
Arredondo-Ochoa T, García-Almendárez BE, Escamilla-García M, Martín-Belloso O, Rossi-Márquez G, Medina-Torres L, Regalado-González C. Physicochemical and Antimicrobial Characterization of Beeswax–Starch Food-Grade Nanoemulsions Incorporating Natural Antimicrobials. International Journal of Molecular Sciences. 2017; 18(12):2712. https://doi.org/10.3390/ijms18122712
Chicago/Turabian StyleArredondo-Ochoa, Teresita, Blanca E. García-Almendárez, Monserrat Escamilla-García, Olga Martín-Belloso, Giovanna Rossi-Márquez, Luis Medina-Torres, and Carlos Regalado-González. 2017. "Physicochemical and Antimicrobial Characterization of Beeswax–Starch Food-Grade Nanoemulsions Incorporating Natural Antimicrobials" International Journal of Molecular Sciences 18, no. 12: 2712. https://doi.org/10.3390/ijms18122712
APA StyleArredondo-Ochoa, T., García-Almendárez, B. E., Escamilla-García, M., Martín-Belloso, O., Rossi-Márquez, G., Medina-Torres, L., & Regalado-González, C. (2017). Physicochemical and Antimicrobial Characterization of Beeswax–Starch Food-Grade Nanoemulsions Incorporating Natural Antimicrobials. International Journal of Molecular Sciences, 18(12), 2712. https://doi.org/10.3390/ijms18122712







